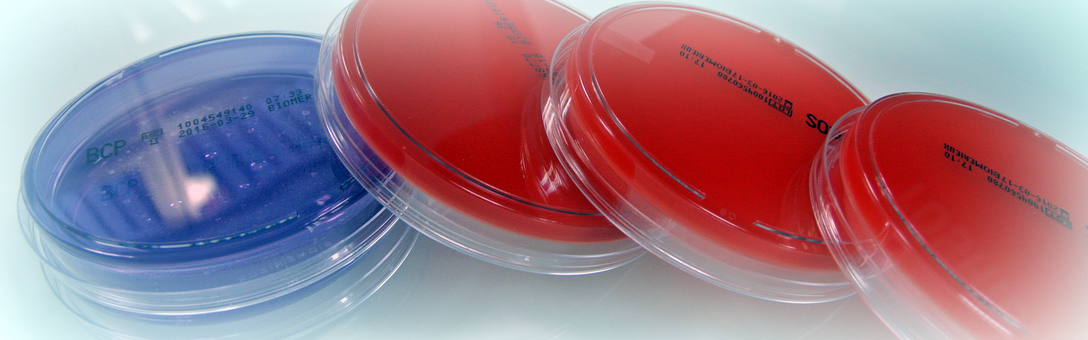

Biopteam
Société de laboratoires de Biologie médicale, nous réalisons vos prélèvements, les analyses et la gestion de vos résultats. L’ensemble de ces activités est réalisé par des professionnels qualifiés et diplômés sous la responsabilité de pharmaciens et de médecins Biologistes. Votre santé est un objectif fondamental, placé au centre de notre politique qualité.